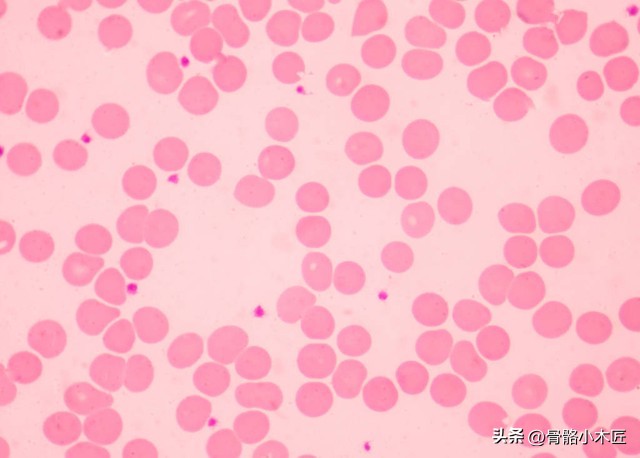
类风湿性关节炎二期表现,类风湿性关节炎二次复发好治吗

#头条文章养成计划#
上一篇我们聊过类风湿性关节炎的病因,临床表现,症状等等,今天我们来了解一下类风湿性关节炎的相关检查及治疗等。
类风湿性关节炎诊断标准:1,晨起关节僵硬至少1小时(≥6周);2,3个或3个以上关节肿胀(≥6周);3,腕/掌指关节或近侧指间关节肿胀(≥6周);4,对称性关节肿胀(≥6周);5,皮下结节;6,手/腕关节X线平片有明确的骨质疏松或骨侵蚀;7,类风湿因子阳性(滴度>1:32)。确认本病需要以上4个或4个以上的标准。

针对类风湿性关节炎检查:
实验室检查:血红蛋白减少,白细胞计数正常或降低,但淋巴细胞计数增加;约70%-80%的患者类风湿因子阳性,但其他结缔组织疾病也可阳性;血沉加快,C-反应蛋白增高,血清LgG/IgA/IgM增高;关节液浑浊/粘稠度降低/黏蛋白凝固了差/糖含量降低,细菌培养阴性。
X线表现:早期关节周围软组织肿大,关节间隙增宽,关节周围骨质疏松,随着病变发展关节周围骨质疏松更加明显,关节面边缘模糊不清,关节间隙逐渐狭窄,晚期关节间隙消失,最终出现骨性强直。
类风湿性关节炎的治疗:此病目前尚无特效疗法,治疗目的在于控制炎症,减轻症状,延缓病情进展,保持关节功能和防止畸形。需要根据不同病人/不同病情制定综合治疗方案。
1,非药物治疗:为一般处理,急性发热及关节疼痛时卧床休息,但应鼓励每天起床适当活动。在一般情况好转时,更要进行关节肌肉活动锻炼,夜间可用支具将关节固定在生理位置,预防关节僵硬,以免发生畸形。
2,药物治疗:目前没有任何药物可以完全阻止病变发展,常用的药物分为三线,第一线药物主要是非甾体类药物,其中昔布类药物的消化道副作用较轻,吲哚美辛是一种非皮质类固醇的消炎/解热/止痛剂,与激素合用,可减少激素的剂量;第二线药物有抗疟药,金盐制剂,柳氮磺胺吡啶,免疫*制剂抑**如青霉胺,甲氨蝶呤等;第三线药物主要是激素。
对于病情较轻,进展较慢的病人,多主张先应用一线药物,必要时联合二线药物;对于病情严重,进展较快的病人,在一线二线药物联合运用的同时,早期给予小剂量激素,以迅速控制症状,见效后逐渐减小药物剂量。

3,手术治疗:早期可行受累关节滑膜切除术,以减少关节炎渗出,防止血管翳形成,保护软骨和软骨下组织,改善关节功能;也可在关节镜下行关节清理,滑膜切除术;晚期,可根据病情行人工关节置换术。
您了解了吗?